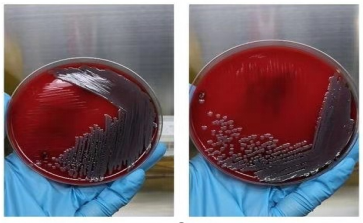

血液里长细菌了怎么办?
血液里怎么会有细菌呢?当然,一般人血液里是不会有细菌的,不然我们吃的营养都会被细菌抢走的。但是有些人生病了之后细菌就会趁虚而入,而且还会在身体里肆意挥霍营养物质,干扰身体各个器官正常运转,甚至休克死亡等严重的后果。那细菌什么情况可能会进入我们身体的呢?
1.发热(>38℃)或低温(<36℃),以间歇热、弛张热多见,革兰阴性杆菌,如大肠埃希菌引起的感染可见双峰热
2.寒战
3.白细胞增多(>10×10-9/L,特别有“核左移”未成熟的粒细胞增多)
4.粒细胞减少(成熟的多核白细胞<1×10-9/L)
5.血小板减少
6.皮肤、粘膜出血,常见于溶血性链球菌感染的菌血症,伤寒病人第4-10天可出现玫瑰疹,斑疹伤寒第4-6天可出现暗红色斑血血症
7.昏迷
8.多器官衰竭
9.血压降低
10.呼吸加快

怎么做才知道我们的血液里有细菌呢?其实很简单,做个血培养就可以了,同时还可以知道是哪种细菌在我们身体里捣乱的。血培养要怎么做呢,和其他抽血差不多,就是消毒要求更严格一些,抽的量一次至少要十几毫升,而且要在不同部位抽两三次,并且放到专门的培养瓶中培养观察结果。

血培养是检测菌血症和真菌血症的简单且准确的一种方法,血是临床诊断血液感染的金标准,也可以用于培养细菌,真菌,厌氧菌和结核菌等引起的菌血症个感染诊断。菌血症和脓毒血症是临床常见危重症,病死率高达20%-50%。在患者的血液中检出病原菌对感染性疾病的诊断、治疗和预后有着重要的临床意义,细菌的药敏结果进一步指导临床合理使用抗生素,早期诊断,可帮助更准确地治疗,缩短患者住院时间,减少治疗费用,减低死亡率。
如何提高血培养阳性率?
1. 从不同部位(如双臂)采集2-3套血培养标本,即“双瓶双侧”。如有必要,可同时或短时间间隔从下肢采血接种第三套培养瓶
2. 及时送检
3. 不能立即送检的切忌冷藏
注意事项:
1.血培养为了防止皮肤寄生菌污染,可使用消毒剂对皮肤进行严格仔细的消毒处理,最大限度地降低皮肤污染。
2.在血液注入血培养瓶之前,用无菌纱布或棉签清除橡皮塞子表面剩余的酒精,然后注入血液。
3.采血量:成人一般抽8~10ml/瓶,不得少于 5ml;婴幼儿不少于2ml。

上一篇: 关于HCG你知多少
下一篇: “D-二聚体”到底是什么?看完你就懂了!




























 版权所有© 国药东风总医院
版权所有© 国药东风总医院  鄂公网安备 42030302000164号
鄂公网安备 42030302000164号